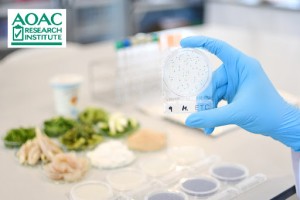
Compact Dry có thực sự chính xác không

Tự động và đơn giản hóa kiểm nghiệm vi sinh với đĩa môi trường đổ sẵn
04:39 13/06/2026Trong bối cảnh ngành thực phẩm, dược phẩm và mỹ phẩm ngày càng chú trọng đến an toàn vi sinh, việc đơn giản hóa và tự động hóa kiểm nghiệm vi sinh...
Doanh nghiệp mất bao nhiêu tiền nếu không kiểm soát vệ sinh?
04:44 06/06/2026Trong môi trường sản xuất thực phẩm, nước uống, dược phẩm hay mỹ phẩm, kiểm soát vệ sinh không chỉ là yêu cầu bắt buộc mà còn là yếu tố quyết định đến...
Ứng dụng Compact Dry trong ngành thực phẩm: Kiểm soát vi sinh nhanh – chính xác
23:30 29/05/2026Trong ngành thực phẩm, đặc biệt là sữa, nước giải khát, thủy sản…, kiểm soát vi sinh là yếu tố quyết định chất lượng và độ an toàn sản phẩm.
Ngành sữa nên chọn phương pháp nào để kiểm tra vi sinh nhanh
23:11 29/05/2026Tại sao kiểm tra vi sinh trong ngành sữa lại quan trọng?
Sai sót khi đổ thạch: Rủi ro tiềm ẩn mà nhiều phòng lab bỏ qua
23:21 22/05/2026Trong quy trình kiểm nghiệm vi sinh truyền thống, bước đổ thạch tưởng chừng đơn giản nhưng lại là nguyên nhân gây ra rất nhiều sai sót.
Mất 2–3 ngày chờ kết quả vi sinh: Doanh nghiệp đang trả giá như thế nào
23:01 22/05/2026Trong ngành thực phẩm, nước uống, thủy sản hay dược phẩm, thời gian kiểm nghiệm vi sinh đóng vai trò cực kỳ quan trọng.
5 lý do phòng lab hiện đại chọn Compact Dry thay vì môi trường truyền thống
23:55 10/04/2026Tìm hiểu 5 lý do phòng lab hiện đại chuyển sang sử dụng đĩa Compact Dry thay vì môi trường truyền thống trong kiểm nghiệm vi sinh để tiết kiệm thời...
Compact Dry có thực sự chính xác không? Phân tích dữ liệu thực tế
05:41 05/04/2026Compact Dry có chính xác không? Cùng phân tích dữ liệu thực tế và so sánh với phương pháp kiểm nghiệm vi sinh truyền thống để đánh giá độ tin cậy.